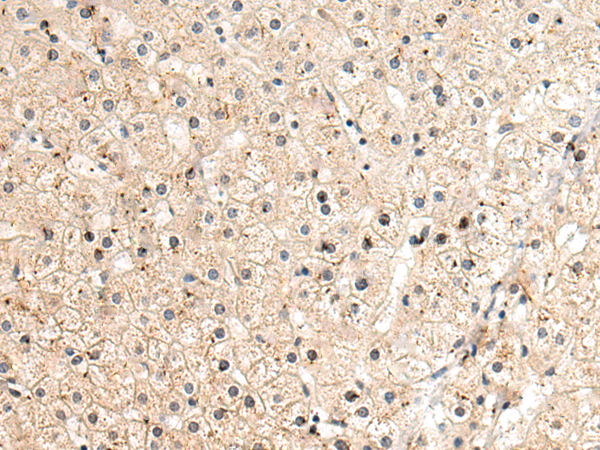

|
Background: |
This gene encodes a long chain base subunit of serine palmitoyltransferase. Serine palmitoyltransferase, which consists of two different subunits, is the key enzyme in sphingolipid biosynthesis. It catalyzes the pyridoxal-5-prime-phosphate-dependent condensation of L-serine and palmitoyl-CoA to 3-oxosphinganine. Mutations in this gene were identified in patients with hereditary sensory neuropathy type I. |
|
Applications: |
ELISA, IHC |
|
Name of antibody: |
SPTLC2 |
|
Immunogen: |
Fusion protein of human SPTLC2 |
|
Full name: |
serine palmitoyltransferase long chain base subunit 2 |
|
Synonyms: |
LCB2; SPT2; HSN1C; LCB2A; NSAN1C; hLCB2a |
|
SwissProt: |
O15270 |
|
ELISA Recommended dilution: |
5000-10000 |
|
IHC positive control: |
Human liver cancer and Human gastric cancer |
|
IHC Recommend dilution: |
100-200 |

購物車
幫助
021-54845833/15800441009
